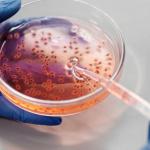
Postaw kropkę nad i w diagnostyce boreliozy: jak test Western blot potwierdza wyniki i przyspiesza drogę do zdrowia

USG Doppler tętnic biodrowych to niedoceniane, ale niezwykle przydatne badanie w podejściu „całościowej profilaktyki naczyniowej” nóg. Pozwala wcześnie wykryć zaburzenia dopływu krwi do kończyn dolnych, lepiej zrozumieć źródła dolegliwości i bezpiecznie zaplanować działania zapobiegające żylakom oraz leczenie niewydolności żylnej. Sprawdź,…
Nowoczesne testy PCR z kału zmieniły sposób diagnozowania pasożytów jelitowych: są szybkie, czułe i potrafią wykryć nawet niewielkie ilości DNA patogenów. Kiedy warto je wykonać, co dokładnie wykrywają i jak przygotować się do pobrania próbki? Poniżej znajdziesz praktyczny przewodnik, który…
Twoje nerki rzadko wysyłają głośne sygnały ostrzegawcze, a gdy zaczynają „mówić”, często jest już późno. Wczesne wykrycie subtelnych uszkodzeń może jednak ochronić ich funkcję na lata. Poznaj praktyczny przewodnik po tym, kiedy rozważyć badanie moczu z markerem nefronowym, jak się…
Retikulocyty to najczulszy, wczesny wskaźnik pracy szpiku i produkcji krwinek czerwonych. Poznaj proste metody liczenia i interpretacji wyników, zobacz kiedy wykonać badanie oraz jak włączyć je do planu profilaktyki anemii, aby zatrzymać niedokrwistość, zanim rozwiną się objawy.
Przezprzełykowe echo serca (TEE) to precyzyjne badanie obrazowe, które rozjaśnia wątpliwości tam, gdzie zwykłe USG serca przez klatkę piersiową nie wystarcza. W tym przewodniku wyjaśniamy, kiedy najlepiej rozważyć TEE, jak się do niego przygotować, jak przebiega i dlaczego – mimo…
Szukasz wiarygodnej drogi do rozpoznania boreliozy i chcesz mieć pewność, że wynik jest nieprzypadkowy? Sprawdź, w jaki sposób test Western blot – stosowany jako krok potwierdzający po badaniu przesiewowym – pomaga „postawić kropkę nad i” w diagnostyce choroby z Lyme.…
Dowiedz się, jak skutecznie chronić się przed rakiem endometrium i przejść przez biopsję bez stresu. W przystępny sposób wyjaśniamy czynniki ryzyka, objawy alarmowe, badania (w tym bezbolesne sposoby na biopsję endometrialną) i konkretne kroki profilaktyki, które możesz wdrożyć już dziś.
Masz zaplanowane nocne EEG i chcesz przejść przez nie spokojnie oraz bez niespodzianek. W tym przewodniku znajdziesz prosty, sprawdzony plan przygotowań krok po kroku: od tygodnia przed badaniem, przez ostatnią dobę, aż po sam wieczór. Dowiesz się, co zabrać, czego…
Biodostępny testosteron to frakcja hormonu naprawdę dostępna dla tkanek – klucz do siły, libido, nastroju i wydolności poznawczej. W tym poradniku wyjaśniamy, kiedy i jakie badania wykonać, jak przygotować się do pobrania krwi oraz jak czytać wyniki, aby zrozumieć swoją…
Koronarografia nie musi budzić lęku. W tym przewodniku, krok po kroku, pokazujemy jak przygotować się do koronarografii serca, co spakować, jak postępować z lekami i jak wygląda sam dzień badania. Przejdziemy przez praktyczną checklistę, odpowiedzi na najczęstsze pytania i wskazówki,…